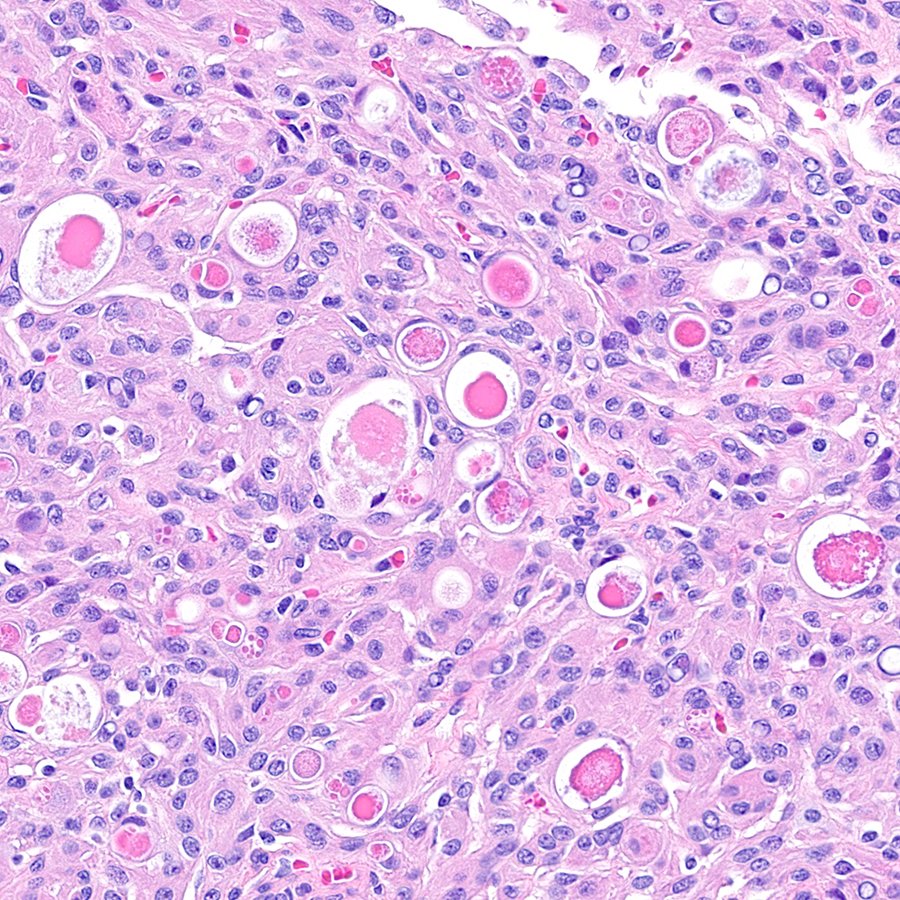

Miguel Reyes-Múgica
@mreyesm
Director- Ped & Perinat Pathol. U Miami. Standing WHO Ed.B. Expert Editor WHO PAED5. Former Yale Professor 1994-2008; Former EIC @PedDevPath (2001-2016).
ID: 37185871
02-05-2009 12:14:03
27,27K Tweet
9,9K Followers
6,6K Following

Y-GTD Case of August 2025: Patient under 20 years of age, G1P0 at 5 weeks by LMP, underwent uterine D&C for an undesired pregnancy. Yale Pathology bit.ly/48Yq1pO



Mi editorial de la semana en La Crónica de Hoy trata sobre las revistas depredadoras y un artículo del PNAS que muestra datos sugerentes de que existen fraudes a nivel masivo. Interesante conocer los datos.